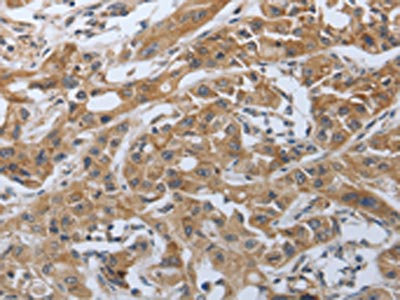

PDCD1 Antibody
-
中文名稱:PDCD1兔多克隆抗體
-
貨號:CSB-PA483633
-
規(guī)格:¥1100
-
圖片:
-
The image on the left is immunohistochemistry of paraffin-embedded Human gastic cancer tissue using CSB-PA483633(PDCD1 Antibody) at dilution 1/50, on the right is treated with synthetic peptide. (Original magnification: ×200)
-
The image on the left is immunohistochemistry of paraffin-embedded Human lung cancer tissue using CSB-PA483633(PDCD1 Antibody) at dilution 1/50, on the right is treated with synthetic peptide. (Original magnification: ×200)
-
-
其他:
產(chǎn)品詳情
-
Uniprot No.:
-
基因名:
-
別名:CD279 antibody; CD279 antigen antibody; hPD 1 antibody; hPD l antibody; hPD-1 antibody; hSLE1 antibody; PD 1 antibody; PD-1 antibody; PD1 antibody; PDCD 1 antibody; PDCD1 antibody; PDCD1_HUMAN antibody; Programmed cell death 1 antibody; Programmed cell death 1 protein antibody; Programmed cell death protein 1 antibody; Protein PD 1 antibody; Protein PD-1 antibody; SLEB2 antibody; Systemic lupus erythematosus susceptibility 2 antibody
-
宿主:Rabbit
-
反應(yīng)種屬:Human
-
免疫原:Synthetic peptide of Human PDCD1
-
免疫原種屬:Homo sapiens (Human)
-
標(biāo)記方式:Non-conjugated
-
抗體亞型:IgG
-
純化方式:Antigen affinity purification
-
濃度:It differs from different batches. Please contact us to confirm it.
-
保存緩沖液:-20°C, pH7.4 PBS, 0.05% NaN3, 40% Glycerol
-
產(chǎn)品提供形式:Liquid
-
應(yīng)用范圍:ELISA,IHC
-
推薦稀釋比:
Application Recommended Dilution ELISA 1:2000-1:10000 IHC 1:50-1:200 -
Protocols:
-
儲存條件:Upon receipt, store at -20°C or -80°C. Avoid repeated freeze.
-
貨期:Basically, we can dispatch the products out in 1-3 working days after receiving your orders. Delivery time maybe differs from different purchasing way or location, please kindly consult your local distributors for specific delivery time.
-
用途:For Research Use Only. Not for use in diagnostic or therapeutic procedures.
相關(guān)產(chǎn)品
靶點詳情
-
功能:Inhibitory receptor on antigen activated T-cells that plays a critical role in induction and maintenance of immune tolerance to self. Delivers inhibitory signals upon binding to ligands CD274/PDCD1L1 and CD273/PDCD1LG2. Following T-cell receptor (TCR) engagement, PDCD1 associates with CD3-TCR in the immunological synapse and directly inhibits T-cell activation. Suppresses T-cell activation through the recruitment of PTPN11/SHP-2: following ligand-binding, PDCD1 is phosphorylated within the ITSM motif, leading to the recruitment of the protein tyrosine phosphatase PTPN11/SHP-2 that mediates dephosphorylation of key TCR proximal signaling molecules, such as ZAP70, PRKCQ/PKCtheta and CD247/CD3zeta.; The PDCD1-mediated inhibitory pathway is exploited by tumors to attenuate anti-tumor immunity and escape destruction by the immune system, thereby facilitating tumor survival. The interaction with CD274/PDCD1L1 inhibits cytotoxic T lymphocytes (CTLs) effector function. The blockage of the PDCD1-mediated pathway results in the reversal of the exhausted T-cell phenotype and the normalization of the anti-tumor response, providing a rationale for cancer immunotherapy.
-
基因功能參考文獻(xiàn):
- HLA-G, NRP1, and PD-1, may be involved in the immune response in psoriatic patients PMID: 29790686
- Proportions of naive CD4+ T cells were lower in young patients than in age-matched controls, and actually comparable to those in old patients and controls. This was accompanied with increased percentages of memory CD4+ T cells expressing HLA-DR, Ki-67, and PD-1 in young melanoma patients in comparison to the age-matched controls, but not in old patients. PMID: 29546435
- This meta-analysis demonstrates the PD-1 rs36084323 A > G polymorphism is associated with decreased cancer risk in Asian PMID: 30249505
- there is no significant association between PD1.3G/A - rs11568821 polymorphism and systemic lupus erythematosus or rheumatoid arthritis susceptibility in Southern Brazilian population. PMID: 27914594
- SLC18A1 might complement other biomarkers currently under study in relation to programmed cell death protein 1/programmed cell death protein ligand 1 inhibition PMID: 30194079
- Structural and functional analyses unexpectedly reveal an N-terminal loop outside the IgV domain of PD-1. This loop is not involved in recognition of PD-L1 but dominates binding to nivolumab, whereas N-glycosylation is not involved in binding at all. PMID: 28165004
- This finding suggested the potential application of PD-1 blockade in AML. The present work demonstrated an excellent synergistic tumour therapeutic effect of PD-1 blockade and CTL therapy compared with either treatment alone. PMID: 29962321
- High PD-1 expression is associated with Mycobacterium avium complex-induced lung disease. PMID: 28169347
- PD-1/PD-L1 expression is a frequent occurrence in poorly differentiated neuroendocrine carcinomas of the digestive system. PMID: 29037958
- Results indicated that high-level PD1 expression may be an important factor associated with the immune checkpoint pathway in liver cancer. PMID: 29620156
- These results suggest that the PD-1 genotype of the donor plays an important role for the development of acute GvHD after alloHSCT from HLA-identical sibling donors. PMID: 30019128
- We conclude that a subgroup of advanced disease ovarian cancer patients with high grade tumors, expressing PD-L1, may be prime candidates for immunotherapy targeting PD-1 signaling PMID: 29843813
- Both rs2227982 and rs2227981 polymorphisms were associated with T1 Diabetes (T1D) risk in East Asians, and rs2227982 also had a significant association with glycemic traits, which suggested PDCD1 gene polymorphisms might participate in facilitating T1D risk. [meta-analysis] PMID: 29774466
- PD.1 (-538G/A) gene polymorphism is associated with Colon Cancer Risk. PMID: 29580042
- The high-affinity PD-1 mutant could compete with the binding of antibodies specific to PD-L1 or PD-L2 on cancer cells. PMID: 29890018
- The G allele of rs36084323 of PDCD1 is associated with increased risk of advanced TNM staging of colorectal cancer. PMID: 29652996
- promoter methylation of CTLA4, PD-L1, PD-L2, and PD-1 in diffuse lower-grade gliomas (LGG) harboring isocitrate dehydrogenase (IDH) mutation, is reported. PMID: 29396294
- Unlike other multiple autoimmune disease associated genetic variants, there was no association between PDCD1 variants and Juvenile Idiopathic Arthritis PMID: 28056736
- Alteration of the PD-1/PD-L1 pathway can modulate Treg/Th17 balance in asthmatic children. PMID: 29874664
- The expression of PD1 on T cells was elevated in patients with rheumatoid arthritis and was correlated with the disease activity. PMID: 29257239
- High expression of programmed death-1 in sentinel lymph nodes is associated with breast cancer. PMID: 29193094
- We describe three cases of patients with mRCC treated with anti-PD-1 antibody therapy in combination with targeted therapy (bevacizumab), anti-cytotoxic T lymphocyte antigen 4 therapy (ipilimumab), or radiotherapy. PMID: 29146617
- anti-CTLA4/anti-PD-1/PD-L1 combinations versus anti-PD-1/PD-L1 monotherapy was selected as a factor independent of TMB for predicting better RR (77% vs. 21%; P = 0.004) and PFS (P = 0.024). Higher TMB predicts favorable outcome to PD-1/PD-L1 blockade across diverse tumors. PMID: 28835386
- The altered soluble (s)PD1 and sICOS serum levels in the different Hepatitis b (HBV) groups may reflect the dysregulation of T cell activation, and may be associated with the HBV pathological process. PMID: 28983583
- We found that PD-L1 expression was upregulated following TGF-beta induction; in contrast, it was downregulated by TGF-beta receptor-kinase inhibitors and the MET process. Furthermore, chemo-treatment increased TGF-beta expression and enhances PD-L1 expression via autocrine TGF-beta induced EMT. Analysis of clinical samples revealed a significant relationship between PD-L1 expression and EMT status PMID: 28849209
- this study demonstrated that PD-1 may involve in lymph nodes metastasis and promote the understanding of the mechanism of immunotherapies in the non-small cell lung cancer PMID: 28799818
- PD-L1 expression in melanoma tumor cells is lower than NSCLC or renal cell carcinoma cells. The higher response rate in melanoma patients treated with PD-1 inhibitors is likely related to PD-L1 in tumor-associated inflammatory cells. Further studies are warranted to validate the predictive role of inflammatory cell PD-L1 expression in melanoma and determine its biological significance PMID: 28223273
- Higher PRE PD-1(+) T cells in responders suggest active suppression of an engaged immune system that is disinhibited by anti-PD-1 therapies. Furthermore, immunoprofiling of EDT biopsies for increased PD-L1 expression and immune cell infiltration showed greater predictive utility than PRE biopsies and may allow better selection of patients most likely to benefit from anti-PD-1 therapies and warrants further evaluation PMID: 28512174
- PD-1 was overexpressed on CD8+ T-cells from patients with Obstructive Sleep Apnoea in a severity-dependent manner. PMID: 29051270
- The results show that the distinctive pathological features of papillary thyroid carcinomas (PTCs), including tumor-infiltrating lymphocytes (TILs), background chronic lymphocytic thyroiditis (CLT), female gender, psammoma bodies, and stromal calcification, are useful parameters for predicting PD-L1 or PD-1 expression. PMID: 28974264
- Our results did not show any association between PDCD1 SNPs and the development of juvenile idiopathic arthritis in an Iranian population PMID: 29307156
- High expressions of programmed cell death protein 1 (PD-1) and programmed cell death 1 ligand 1 (PD-L1) were associated with poor prognosis after surgery. PMID: 29848685
- Programmed death-1 polymorphism is associated with risk of esophagogastric junction adenocarcinoma. PMID: 28487496
- PD-1 was expressed in 26% of Ewing's sarcoma family of tumor cells and may have prognostic and therapeutic implications PMID: 29445891
- We now show that patients with low PD-L1 expression on myeloid cells have improved survival when treated with an antitumor vaccine, suggesting that PD-L1 expression on myeloid cells may be an important predictive biomarker in future clinical trials. Additionally, the combination of PD-1/PD-L1 inhibition and vaccination may increase the efficacy of this immunotherapeutic approach. PMID: 28193626
- Lower expression of PD-1 and PD-L1 was associated with better survival in patients who underwent surgery for the primary tumor and had multiple brain metastases PMID: 28201746
- PD-1/PD-L pathway inhibits Mycobacterium tuberculosis-specific CD4(+) T-cell functions and phagocytosis of macrophages in active tuberculosis. PMID: 27924827
- This study builds optimism that harmonization between assays may be possible, and that the three assays studied could potentially be used interchangeably to identify patients most likely to respond to anti-PD-1/PD-L1 immunotherapies, provided the appropriate clinically defined algorithm and agent are always linked. PMID: 28073845
- Results identified an overall low expression of PD-1 and PD-L1 in high-risk prostate cancer tissue. PMID: 28461179
- The biopsy tumor key protein measurements demonstrate substantial between-tumor variation in expression ratios of these proteins and suggest that programmed cell death 1 ligand 2 PD-L2 is present in some tumors at levels sufficient to contribute to programmed cell death-1 PD-1-dependent T-cell regulation and possibly to affect responses to PD-1- and programmed cell death 1 ligand 1 PD-L1-blocking drugs. PMID: 28546465
- Early phase clinical trials using PD-1 or PD-L1 inhibitors alone or in combination have shown objective tumor responses and durable long-term disease control, in heavily pre-treated patients, notably in the TN subtype. Blockade of PD-1 or PD-L1 shows impressive antitumor activity in some subsets of breast cancer patients PMID: 28799073
- Differential expression of immunological markers relating to the PD-1/PD-L1 pathway in blood can be used as potential diagnostic and prognostic markers in ovarian cancers. These data have implications for the development and trial of anti-PD-1/PD-L1 therapy in ovarian cancer. PMID: 27986748
- LAG-3+ iTILs are enriched in estrogen receptor-negative breast cancers and represent an independent favorable prognostic factor. In addition, a high proportion of PD-1/PD-L1+ tumors are co-infiltrated with LAG-3+ TILs. PMID: 29045526
- An IDO1 inhibitor, epacadostat also demonstrated promising activity in combination with the PD-1 checkpoint inhibitors in other solid tumors, including melanoma, urothelial carcinoma, renal cell carcinoma, and non-small cell lung cancer PMID: 28760910
- PD-L1 was positive in tumor cells in 2/13 cases, weak positive in 7/13, and negative in 4/13 cases, respectively PMID: 28807336
- we report the first case of immune microenvironment profiling and response to anti-PD-1 in a patient with Renal medullary carcinoma to our knowledge. This case suggests that anti-PD-1 based therapies may have clinical activity in Renal medullary carcinoma PMID: 28105368
- We present two cases of metastatic melanoma treated with nivolumab and pembrolizumab (anti PD-1). Both patients developed acute interstitial nephritis during immune checkpoint therapy PMID: 28105370
- the positive rate of PD-L2 did not show any differences between primary tumors and metastatic lymph nodes. In multivariate analysis, PD-L1 expression, PD-L2 expression, a low density of CD8(+) T cells in primary tumors, and PD-1 expression on CD8(+) T cells in primary tumors were associated with poor prognosis. PMID: 28754154
- Relative to controls, the expression of PD-1 and PD-L1 on peripheral blood and tumor infiltrating T cells increased with disease progression. Upregulation of expression promotes t-cells apoptosis in gastric adenocarcinoma. PMID: 29599324
- These data support the combinatorial approach of in situ suppression of the PD-L inhibitory checkpoints with DC-mediated IL15 transpresentation to promote antigen-specific T-cell responses and, ultimately, contribute to graft-versus-tumor immunity PMID: 28637876
顯示更多
收起更多
-
相關(guān)疾病:Systemic lupus erythematosus 2 (SLEB2)
-
亞細(xì)胞定位:Cell membrane; Single-pass type I membrane protein.
-
數(shù)據(jù)庫鏈接:
Most popular with customers
-
-
YWHAB Recombinant Monoclonal Antibody
Applications: ELISA, WB, IHC, IF, FC
Species Reactivity: Human, Mouse, Rat
-
Phospho-YAP1 (S127) Recombinant Monoclonal Antibody
Applications: ELISA, WB, IHC
Species Reactivity: Human
-
-
-
-
-